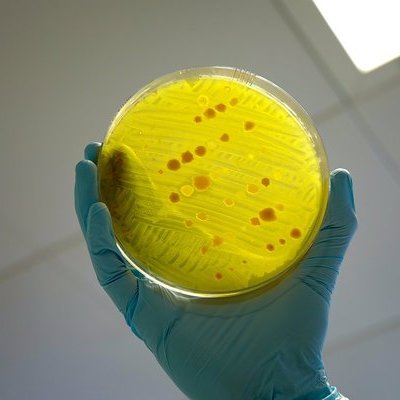

Эксперт рассказала, насколько опасны новые стрептококковые инфекции, распространяющиеся в Восточной Азии
Кандидат биологических наук и ведущий сотрудник Института общей генетики РАН Марина Фридман в беседе с NewsInfo. Ru подчеркнула широкую природу стрептококковых инфекций, которые сейчас распространяются в Востойной Азии. Они могут входить в организм разными путями, от поврежденных участков кожи до орального контакта. Фридман отметила, что некоторые штаммы могут вырабатывать токсины, вызывающие дополнительные разрушения в организме.
Вспышки таких инфекций случаются периодически, с различными возбудителями появляющимися в разных странах, включая, например, Японию и Канаду. Важно, что эти инфекции вызваны бактериями, которые эффективно лечатся антибиотиками.
Вопреки опасениям, новый возбудитель не является вирусом, а значит его передача и лечение отличаются от вирусных инфекций. Несмотря на потенциальную возможность воздушной передачи, что вызывает обеспокоенность и предложения носить маски в некоторых регионах, массовая эпидемия маловероятна.
Фридман также упоминула о периодическом появлении новых бактерий, которые могут приспосабливаться и вырабатывать токсины, но научное сообщество активно разрабатывает методы борьбы с такими угрозами, включая антитоксические сыворотки.
Марина Фридман комментирует:
"Это не вирус. Это уже его положительная черта. Это бактерия".
Ранее мы сообщали о новом вирусе, распространяющемся в Китае.
Фото: flickr. com/DFID — UK Department for International Development (Creative Commons Attribution 2.0 Generic license)
Подписывайтесь на NewsInfo.Ru














